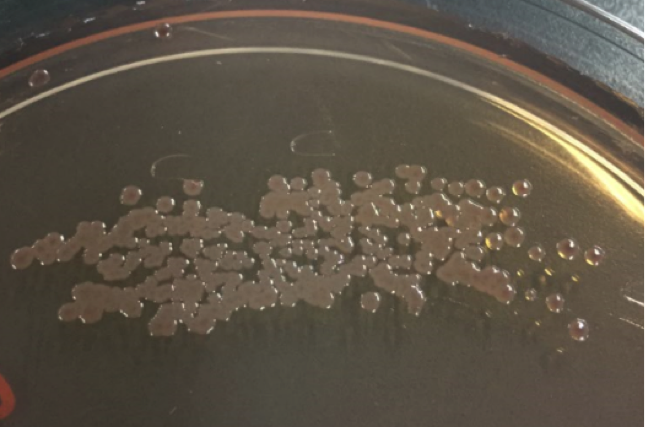
O-157の菌コロニー所見

記事1『O-157による腸管出血性大腸菌感染症の予防』では、O-157による腸管出血性大腸菌感染症の予防についてご説明しました。本記事では、O-157による腸管出血性大腸菌感染症の原因と感染経路について、国際医療福祉大学医学部感染症学講座の松本哲哉(まつもと てつや)先生にお話を伺います。
腸管出血性大腸菌感染症の原因
大腸菌の一種であるO-157が原因菌であることが多い
O-157は、あくまで大腸菌の一種です。菌が持つO抗原には180以上の種類がありますが、そのうち157番目のO抗原のタイプを「O-157」と呼んでいます。
検査の際には、O-157という血清(血液が凝固したとき上澄みにできる淡黄色の液体成分)をあてて反応を確認します。

O-157は少量でも感染を引き起こしやすいといわれている
体内に入る菌量は、感染症を引き起こすかどうかの重要なファクターになる可能性があります。O-157は、食中毒の原因となる菌のなかでも、かなり少量で感染を起こしやすいといわれています。
O-157による腸管出血性大腸菌感染症の感染経路
牛肉汚染が多い
O-157による腸管出血性大腸菌感染症の感染経路は、元をたどれば牛肉の汚染が多いです。
基本的に牛は腸内にO-157を持っており、解体作業の行程で牛肉の表面にO-157が付着します。(=牛肉汚染)その後、牛肉は食品工場へ運ばれ、加工される行程でほかの食品にO-157が移る可能性もあります。
牛を放牧している場所で土壌が汚染して、近くで育てている野菜がO-157に汚染することもあります。また、O-157に感染した人が調理をして食材を汚染させた結果、その料理を食べて感染することもあります。

O-157による腸管出血性大腸菌感染症に感染しやすい場所は?
統計的に感染頻度が高いのは店舗型飲食店
統計的にO-157の感染の頻度が高い場所は、店舗型飲食店です。しかしながら家庭内、学校や園、屋外の飲食店など、場所を問わず感染のリスクは常に存在します。
医師の方へ
様々な学会と連携し、日々の診療・研究に役立つ医師向けウェビナーを定期配信しています。
情報アップデートの場としてぜひご視聴ください。
関連記事

関連の医療相談が11件あります
O157の発生源や原因食品
O157の発生源となるものが知りたいです。(動物・人・食品など…?) また、具体的に取り扱いに注意した方がよい食品を教えてほしいです。肉だけでなく魚や野菜も注意が必要なのでしょうか。
血便が出る
今日、トイレに行ったら、血便が出ていました。 がんなどが心配されるのでしょうか? また、病院に行くとしたら何科にかかったら良いでしょうか?
血便について
先週土曜日に排便時、トイレットペーパーに鮮血が付着していました。肛門外科に行ったのですが、いぼ痔は見られるものの大きなものは認められませんでした。3日後に受診したこともあり、出血箇所が特定しづらいとのことでしたが、排便時のいきみや便秘等で切れた可能性があること、1年前に大腸カメラで異常がなかったことから、少し様子を見るように言われました。 しかし、また今日排便時にトイレットペーパーに鮮血が付着していました。痛みもなく、現在生理4日目(終わりかけ)なのでその血なのかもしれませんが、大腸カメラを再度受けたほうがいいか不安です。下痢や便秘などの不調は1年前からちょこちょこあり、1年前の大腸カメラはその時に受けたものです。 直腸カメラもしくは大腸カメラの検査をしたほうがいいでしょうか?
胃痛と熱発が続く
4,5日ほど前から胃痛があり(1ヶ月ほど前から1~2週間、胃痛がある期間を繰り返していました)、内科を受診しました。その時の熱は36.8℃で、胃炎や食道炎の可能性はあるが、胃薬を処方され様子を見ることになりました。下痢などはありませんでした。 同日夕方、38℃近くの熱発、夜には38.5℃程度まで上がり、翌日の朝~昼過ぎまでは36.9℃程度でした。 胃痛が治まらず夜間は熱が出るため、朝病院を受診し、お腹が少しゴロゴロいっているのと喉が少し赤いと言われ、抗生物質と胃薬、整腸剤などを処方してもらいました。食欲はあまりなく、ゼリーとうどんを少し食べたくらいです。一応PCR検査を受けることになり、検体を提出しました。 その日の夜も38.5℃程度の熱が出て、翌日の朝も38℃前後の熱が出ています。頭痛と胃痛はあっても、嘔吐や喉の痛みや咳、呼吸苦などはありません。味覚・嗅覚も正常です。 新型コロナウイルスに感染している可能性は高いのでしょうか?もしそうでなければ、どのような病気が考えられるのでしょうか?
※医療相談は、月額432円(消費税込)で提供しております。有料会員登録で月に何度でも相談可能です。
「腸管出血性大腸菌感染症」を登録すると、新着の情報をお知らせします

